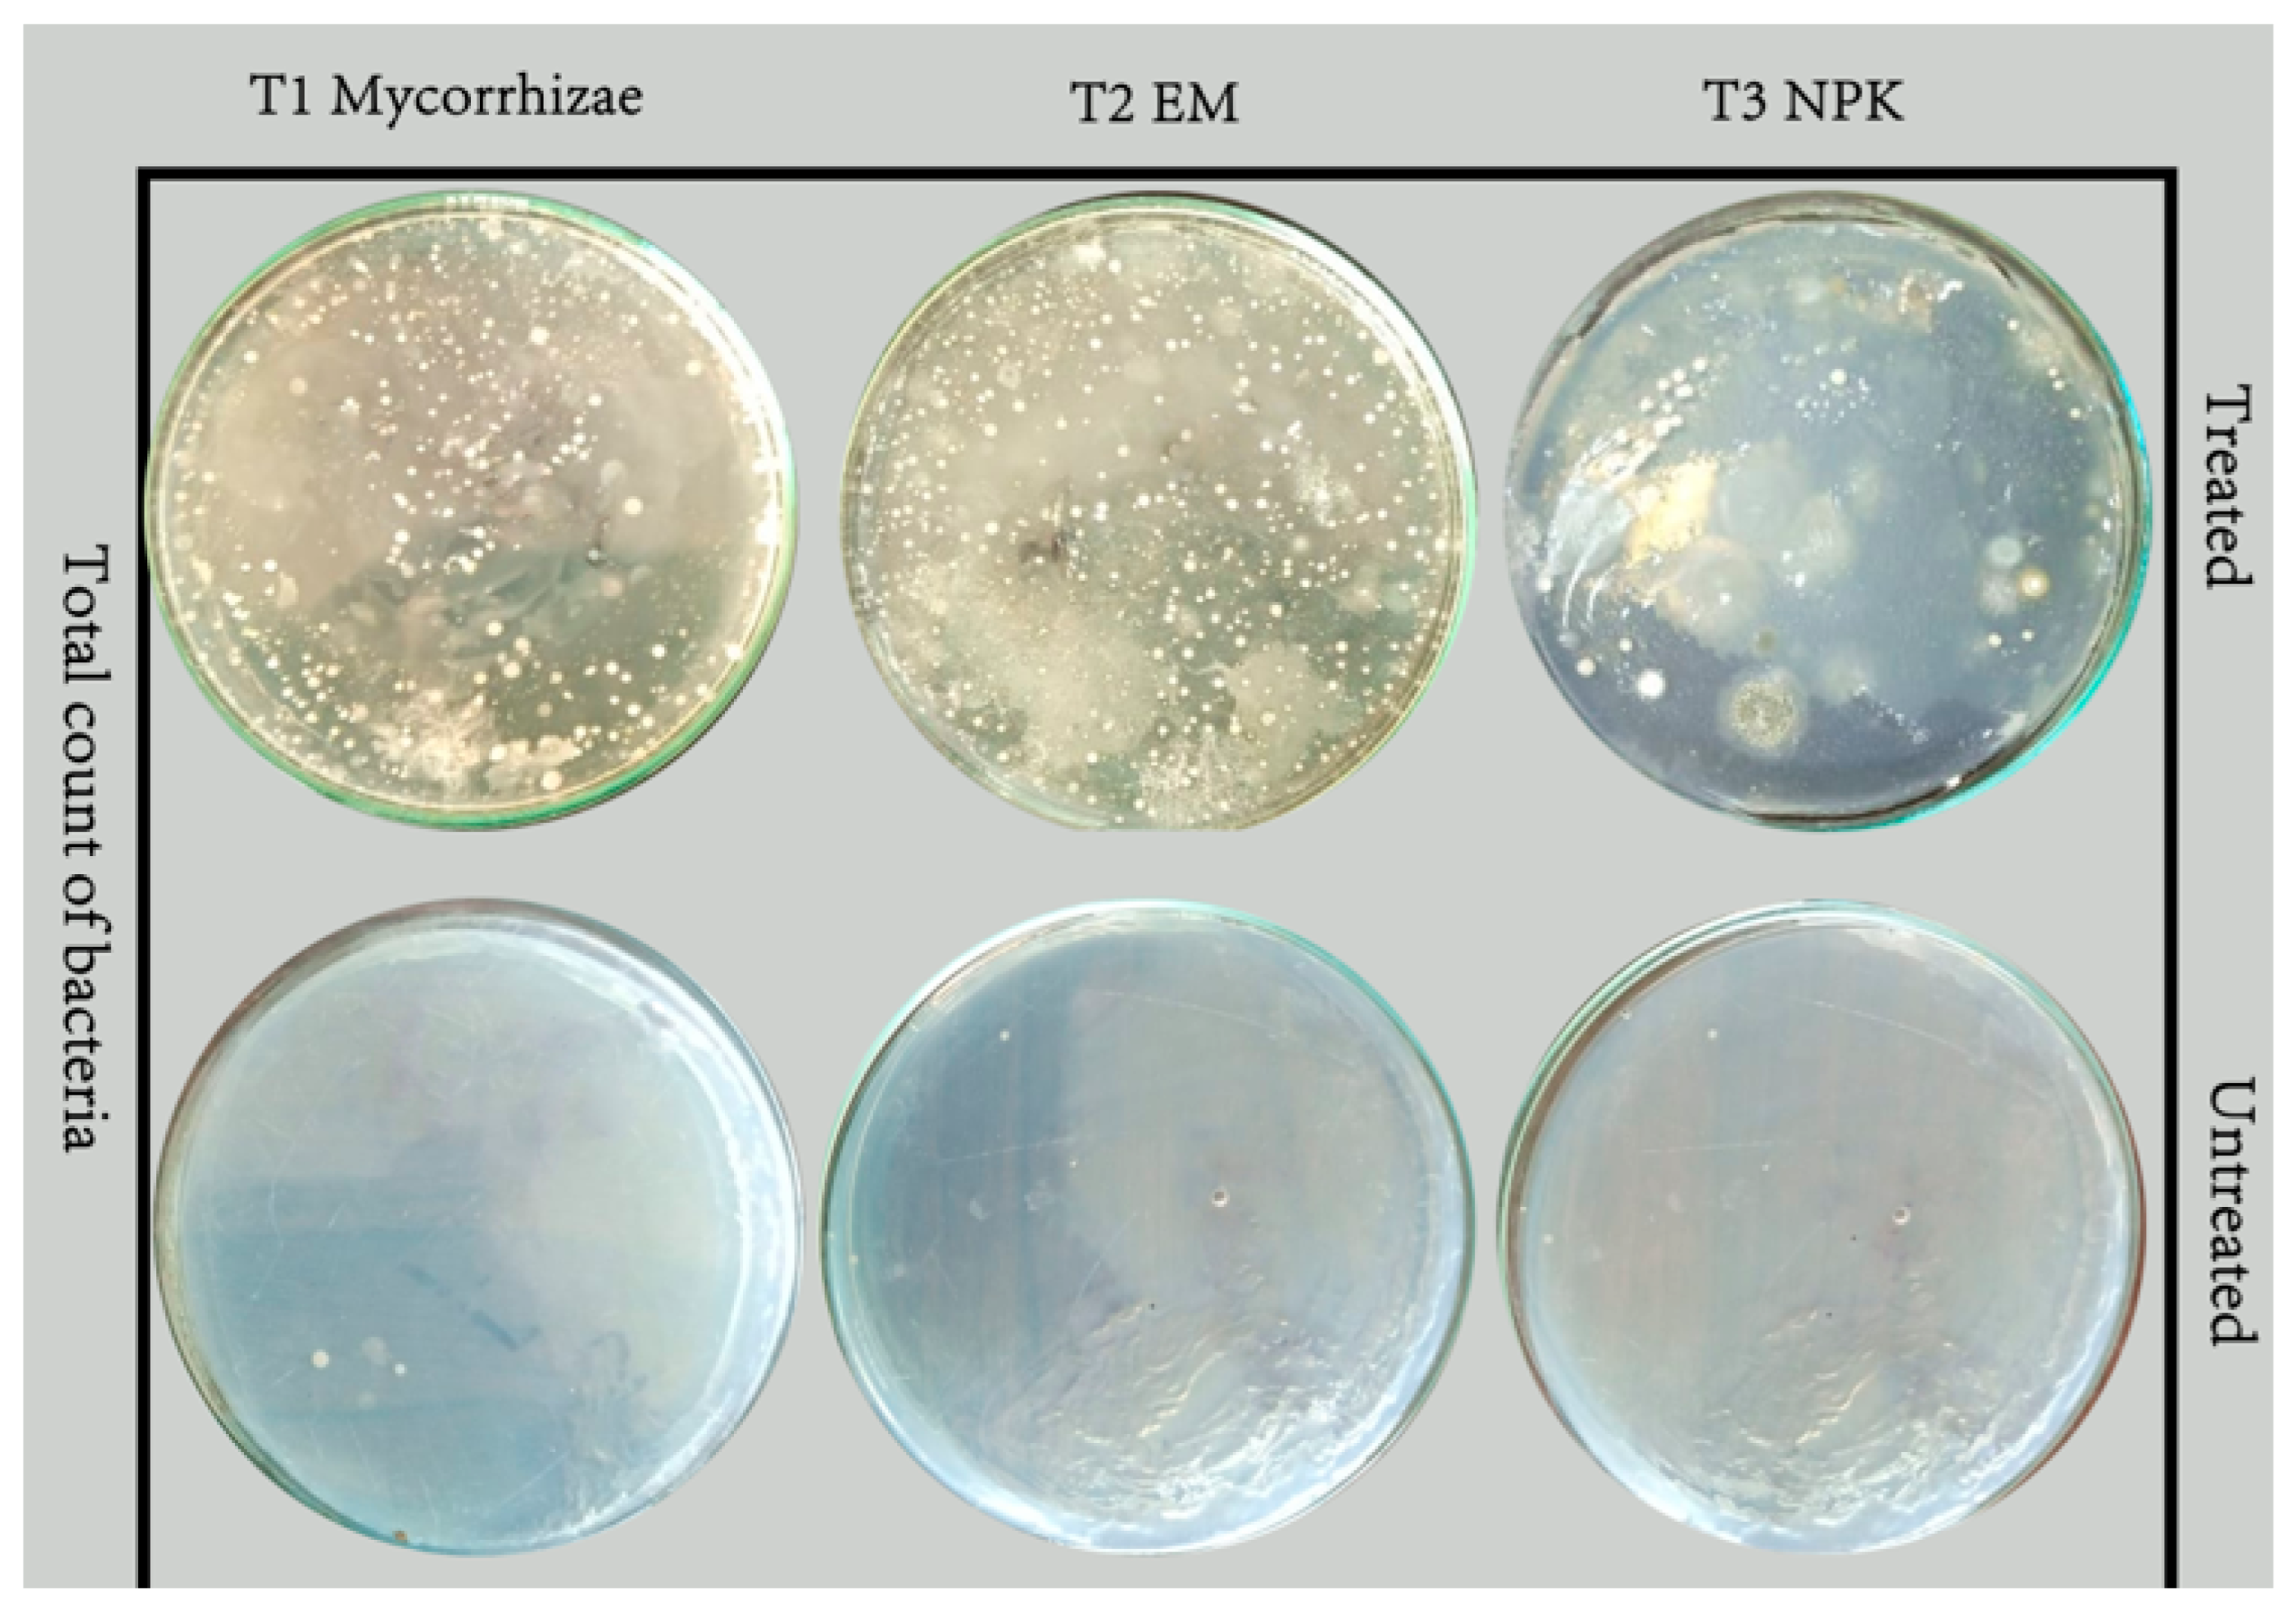
Agronomy 13 02477 g004 Agronomy 13 02477 g004
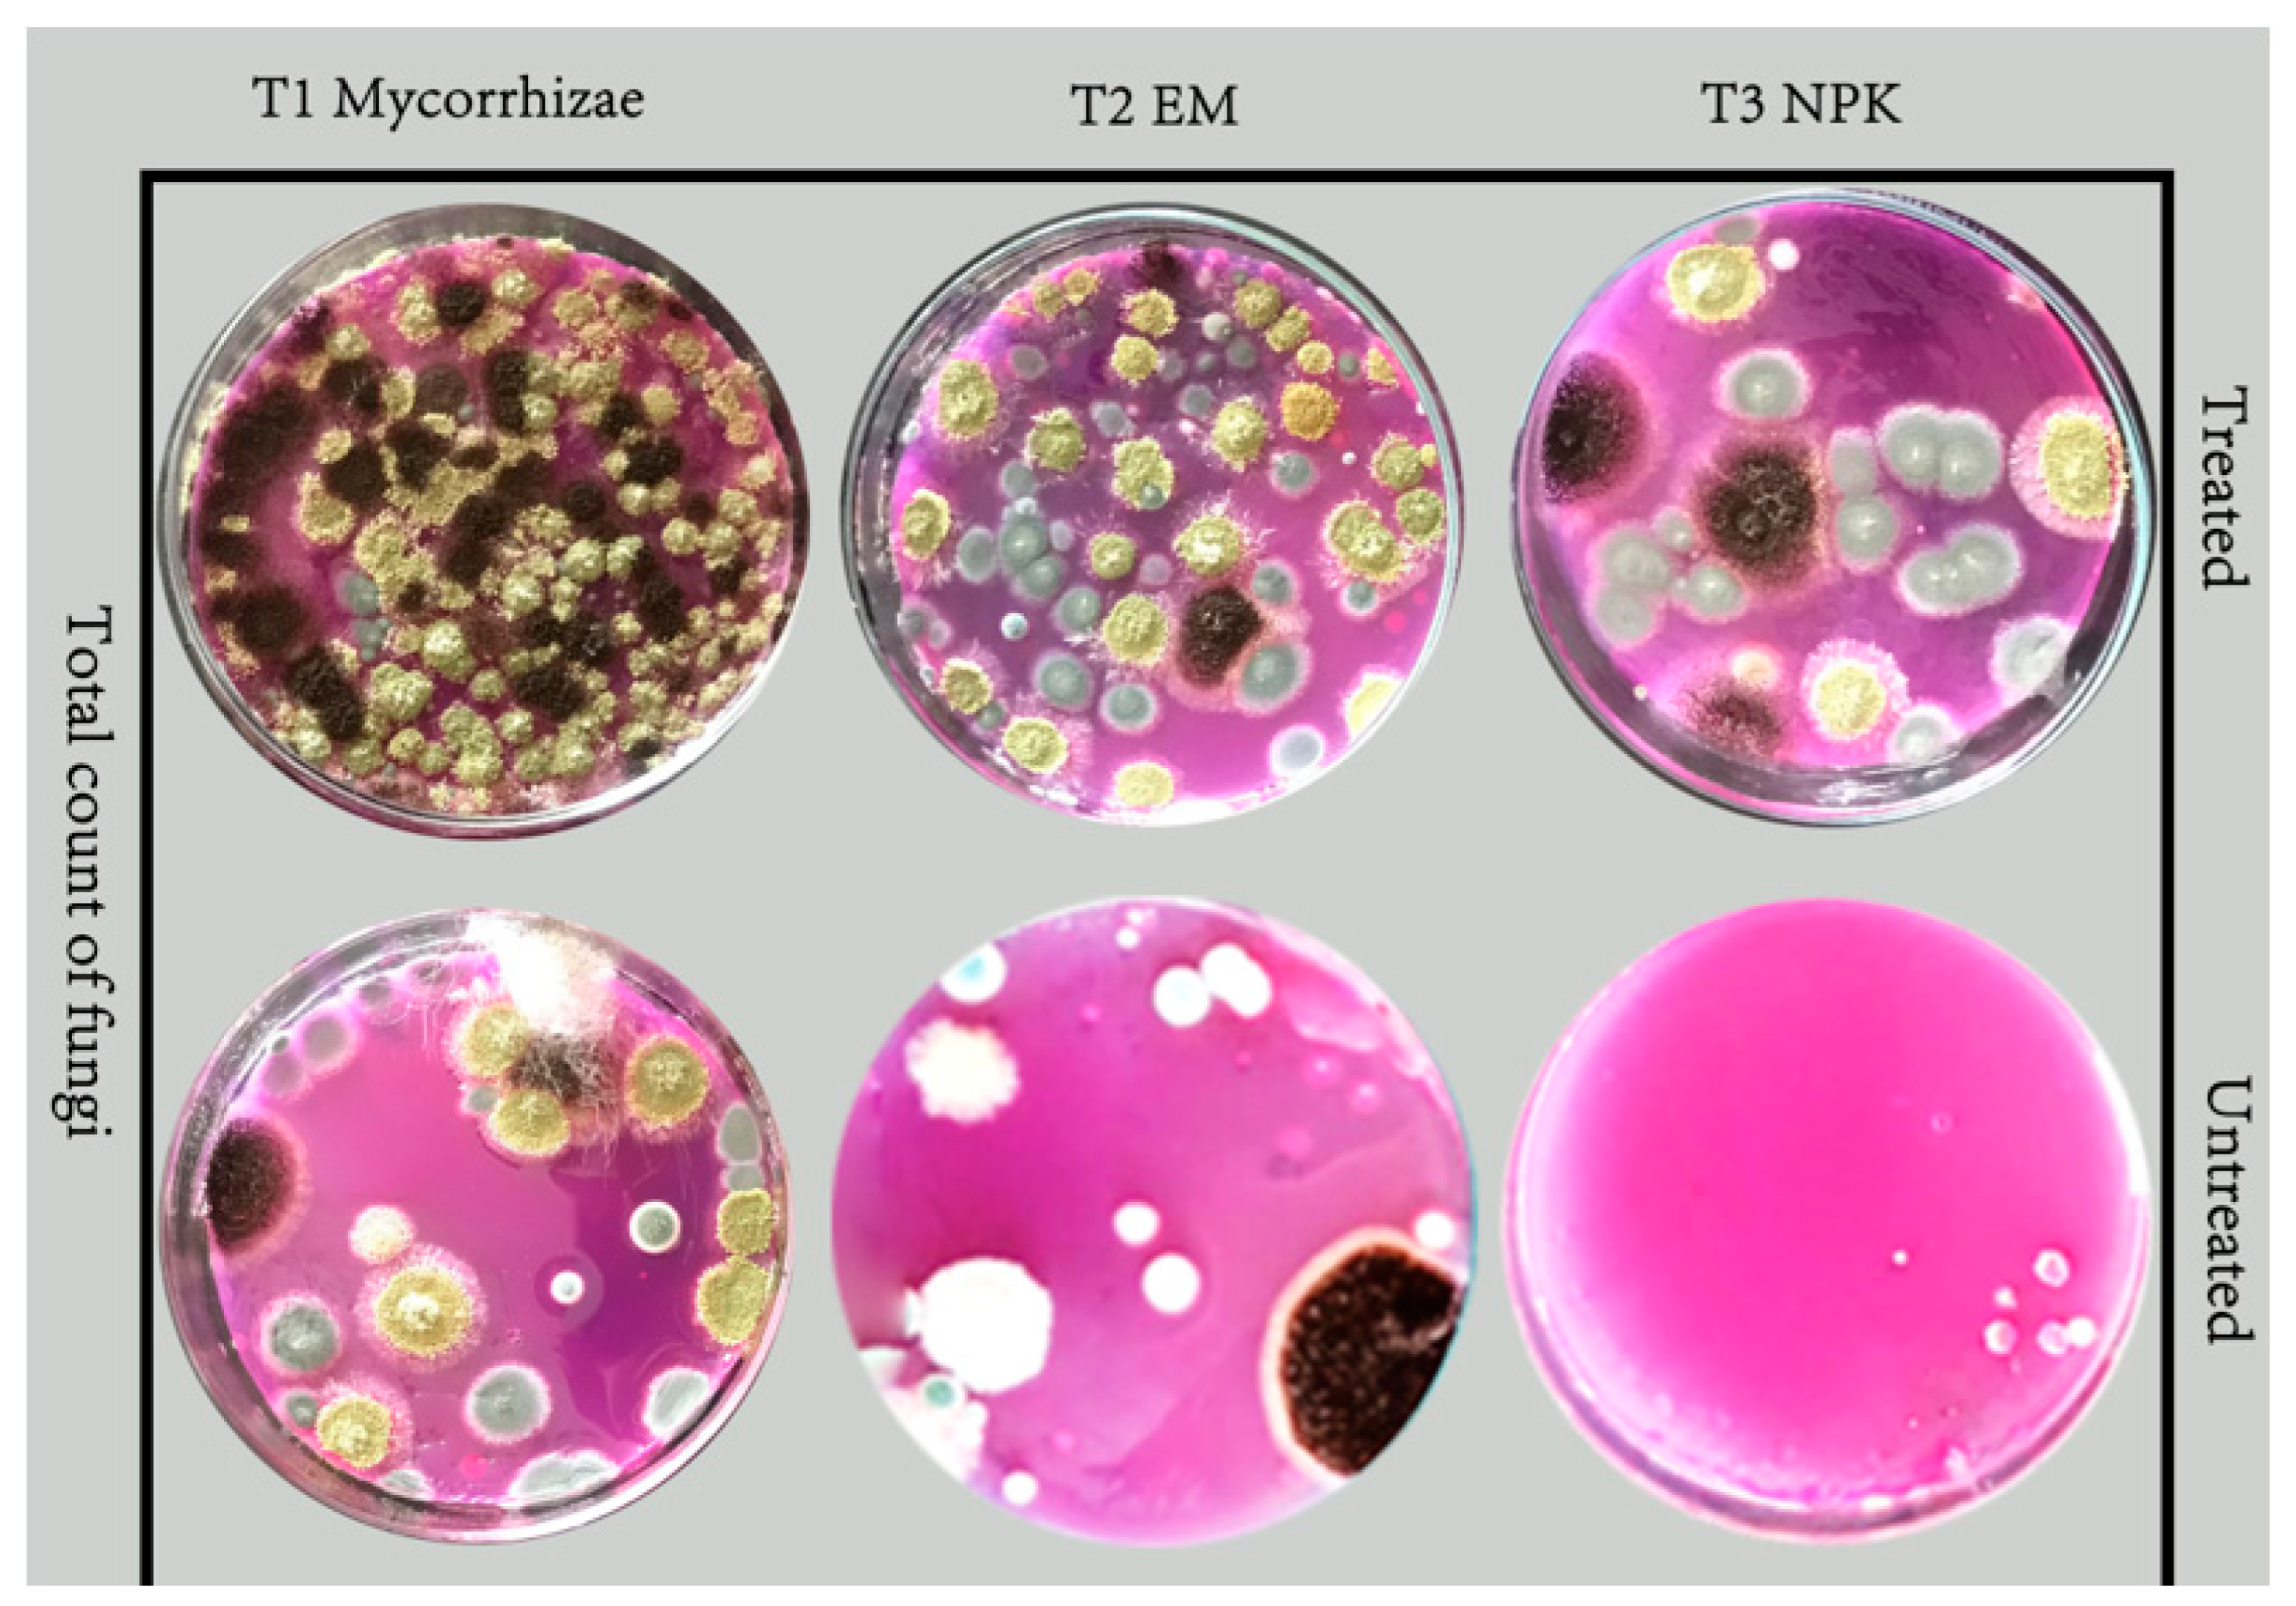
Agronomy 13 02477 g005 Agronomy 13 02477 g005

Exploration of the Benefits of Biofertilizers for Attaining Food Security in Egypt’s Agriculture
Abstract
1. Introduction
2. Materials and Methods
2.1. Studied Plant Species
2.2. Soil and Biofertilizers
2.3. Experimental Design
2.4. Data Recorded
2.5. Determination of the Degree of Mycorrhizal Colonization
2.6. Total Counts of Bacteria, Fungi and Actinomycetes
2.7. Soil Analysis
2.8. Statistical Analyses
3. Results
3.1. Growth and Yield Characters
3.1.1. Potato
Plant production and yield per hectare
Fresh Weight of Single Potato Tubers and Dry Weight of 100 g Fresh Weight
Disease Infection in Produced Potato Tubers
3.1.2. Onion
Plant Fresh Weight and Plant Length
Total Yield (t ha−1)
Dry Weight of 100 g of Onion Fresh Slices
Disorders in Onion Bulbs
Onion Bulb Rot and Sprouting
3.2. Effect of Mycorrhizae, Effective Microorganisms (EMs) and Doses Integrated with 75% of the Recommended NPK on Some Soil Properties
3.3. Effect of Bio- and Mineral Fertilizers on Total Counts of Bacteria, Fungi, Actinomycetes and Mycorrhizal Colonization
4. Discussion
5. Conclusions
Author Contributions
Funding
Data Availability Statement
Acknowledgments
Conflicts of Interest
References
- FAO. The State of Food and Agriculture 2016. Climate Change, Agriculture and Food Security; FAO: Rome, Italy, 2016. [Google Scholar]
- Godfray, H.C.J.; Beddington, J.R.; Crute, I.R.; Haddad, L.; Lawrence, D.; Muir, J.F.; Pretty, J.; Robinson, S.; Thomas, S.M.; Toulmin, C. Food security: The challenge of feeding 9 billion people. Science 2010, 327, 812–818. [Google Scholar]
- Lal, R. Food security in a changing climate. Ecohydrol. Hydrobiol. 2013, 13, 8–21. [Google Scholar]
- Rykaczewska, K. The impact of high temperature during growing season on potato cultivars with different response to environmental stresses. Am. J. Plant Sci. 2013, 4, 2386–2393. [Google Scholar]
- Gul, Z.; Khan, A.A.; Jami, K. Review: Study of Potato leaf roll virus (PLRV) of Potato in Pakistan. Can. J. Sci. Ind. Res. 2011, 2, 24. [Google Scholar]
- Hailu, D.M.; Mosisa, C. Role of Nitrogen on Potato Production: A Review. J. Plant Sci. 2019, 7, 36–42. [Google Scholar]
- Chindi, A.; Shunka, E.; Solomon, A.; Gebremedhin, W.G.; Seid, E.; Tessema, L. Participatory potato seed production: A breakthrough for food security and income generation in the central highlands of Ethiopia. Open Agric. 2017, 2, 205–212. [Google Scholar]
- Devaux, A.; Kromann, P.; Ortiz, O. Potatoes for sustainable global food security. Potato Res. 2014, 57, 185–199. [Google Scholar] [CrossRef]
- FAO. World Food and Agriculture Statistical Pocketbook 2019; Food and Agriculture Organization of the United Nations: Rome, Italy, 2019; 248p. [Google Scholar]
- Hussein, M.; Hassan, M.; AboElyousr, K. Biological control of Botrytis allii by Trichoderma viride on onion Allium cepa. World App. Sci. J. 2014, 32, 522–526. [Google Scholar]
- Gupta, R.; Khokhar, M.K.; Lal, R. Management of the black mould disease of Onion. J. Plant Pathol. Microb. 2012, 3, 133. [Google Scholar] [CrossRef]
- Kumar, P.; Dubey, R.C.; Maheshwari, D.K. Bacillus strains isolated from rhizosphere showed plant growth promoting and antagonistic activity against phytopathogens. Microbiol. Res. 2012, 16, 493–499. [Google Scholar]
- Anonymous. Annual Progress Report for Kharif, 1998; Division of Plant Pathology, S.K. University of Agriculture Science and Technology (Kashmir): Srinagar, India, 2001; 34p. [Google Scholar]
- Harman, G.; Khadka, R.; Doni, F.; Uphoff, N. Benefits to plant health and productivity from enhancing plant microbial symbionts. Front. Plant Sci. 2020, 11, 610065. [Google Scholar] [CrossRef]
- Kumar, S.; Kumar, S.; Mohapatra, T. Interaction between macro- and micro-nutrients in plants. Front. Plant Sci. 2021, 12, 665583. [Google Scholar] [CrossRef]
- Vishwakarma, K.; Kumar, N.; Shandilya, C.; Mohapatra, S.; Bhayana, S.; Varma, A. Revisiting plant–microbe interactions and microbial consortia application for enhancing sustainable agriculture: A review. Front. Microbiol. 2020, 11, 560406. [Google Scholar] [CrossRef] [PubMed]
- Mahanty, T.; Bhattacharjee, S.; Goswami, M.; Bhattacharyya, P.; Das, B.; Ghosh, A.; Tribedi, P. Biofertilizers: A potential approach for sustainable agriculture development. Environ. Sci. Pollut. Res. 2016, 24, 3315–3335. [Google Scholar] [CrossRef] [PubMed]
- Verma, M.; Mishra, J.; Arora, N.K. Plant Growth-Promoting Rhizobacteria: Diversity and Applications. Environ. Biotechnol. Sustain. Future 2018, 2019, 129–173. [Google Scholar]
- Bhardwaj, D.; Ansari, M.W.; Sahoo, R.K.; Tuteja, N. Biofertilizers function as key player in sustainable agriculture by improving soil fertility, plant tolerance and crop productivity. Microb. Cell Fact. 2014, 13, 66. [Google Scholar] [CrossRef] [PubMed]
- Parani, K.; Saha, B.K. Prospects of using phosphate solubilizing Pseudomonas as biofertilizer. Eur. J. Biol. Sci. 2012, 4, 40–44. [Google Scholar]
- Chaudhary, P.; Sharma, A. Response of nanogypsum on the performance of plant growth promotory bacteria recovered from nanocompound infested agriculture field. Environ. Ecol. 2019, 37, 363–372. [Google Scholar]
- Agri, U.; Chaudhary, P.; Sharma, A.; Kukreti, B. Physiological response of maize plants and its rhizospheric microbiome under the influence of potential bioinoculants and nanochitosan. Plant Soil 2022, 474, 451–468. [Google Scholar] [CrossRef]
- Rachid, L.; Said, E.; Nabil, R.; Jihane, K.; Qassim, E.; Hajar, E.; Zineb, B.; Essaid, A.B. Biological Control of Plant Pathogens: A Global Perspective. Microorganisms 2022, 10, 596. [Google Scholar]
- Kabeil, S.S.; Amer, M.A.; Matarand, S.M.; El-Masry, M.H. In planta biological control of potato brown rot disease in Egypt. World J. Agric. Sci. 2008, 4, 803–810. [Google Scholar]
- Alef, K. Soil respiration. In Methods in Applied Soil Microbiology and Biochemistry; Alef, K., Nannipieri, P., Eds.; Academic Press: London, UK, 1995; pp. 214–218. [Google Scholar]
- Knudsen, I.M.B.; Debosz, K.; Hockenhull, J.; Jensen, D.F.; Elmholt, S. Suppressiveness of organically and conventionally managed soils towards brown foot rot of barley. Appl. Soil Ecol. 1995, 12, 61–72. [Google Scholar] [CrossRef]
- Gee, G.; Bauder, J. Particle-size analysis. In Methods of Soil Analysis. Part 1. Physical and Mineralogical Methods; Klute, A., Ed.; SSSAJ: Madison, WI, USA, 1986; pp. 383–411. [Google Scholar]
- Nelson, D.A.; Sommers, L.E. Total carbon, organic carbon, and organic matter. In Methods of Soil Analysis: Part 2 Chemical and Microbiological Properties; SSSA: Madison, WI, USA, 1983; Volume 9, pp. 539–579. [Google Scholar]
- Bremner, J.M. Nitrogen-total. In Methods of Soil Analysis: Part 3: Chemical Methods; SSSA: Madison, WI, USA, 1996; Volume 5, pp. 1085–1121. [Google Scholar]
- Olsen, S.; Sommers, L.; Page, A. Methods of Soil Analysis. Part: 1; SSSA: Madison, WI, USA, 1982; Volume 2, pp. 403–430. [Google Scholar]
- Gomez, K.A.; Gomez, A.A. Statistical Procedures for Agricultural Research, 2nd ed.; John Wiley and Sons: New York, NY, USA, 1984; p. 680. [Google Scholar]
- Pansu, M.; Gautheyrou, J. Analysis of extractable and total elements. In Handbook of Soil Analysis: Mineralogical, Organic and Inorganic Methods; Springer: Berlin/Heidelberg, Germany, 2006; pp. 895–974. [Google Scholar]
- Alori, E.T.; Babalola, O.O. Microbial inoculants for improving crop quality and human health in Africa. Front. Microbiol. 2018, 9, 2213. [Google Scholar] [CrossRef] [PubMed]
- Htwe, A.Z.; Seinn, M.M.; Soe, K.M.; Moe, K.; Yamakawa, T. Effects of Biofertilizer Produced from Bradyrhizobium and Streptomyces griseoflavus on Plant Growth, Nodulation, Nitrogen Fixation, Nutrient Uptake, and Seed Yield of Mung Bean, Cowpea, and Soybean. Agronomy 2019, 9, 77–89. [Google Scholar] [CrossRef]
- Bhupenchandra, I.; Devi, S.H.; Basumatary, A.; Dutta, S.; Singh, L.K.; Kalita, P. Bio stimulants: Potential and prospects in agriculture. Int. Res. J. Pure Appl. Chem. 2020, 21, 20–35. [Google Scholar] [CrossRef]
- Rouphael, Y.; Colla, G. Editorial: Biostimulants in agriculture. Front. Plant Sci. 2020, 11, 40. [Google Scholar] [CrossRef]
- Moustafa, Y.M.M.; Hammam, A.A.; Haddad, S.A. Potassium Humate Application and Cutting Immature Flowers affect Soil Properties, Microbial Activity and Jerusalem Artichoke Yield Components. J. Soil Sci. Agric. Eng. Mansoura Univ. 2018, 9, 33–41. [Google Scholar] [CrossRef]
- Gaur, V. Biofertilizer—Necessity for Sustainability. J. Adv. Dev. 2010, 1, 7–8. [Google Scholar]
- Kannaiyan, S. Biofertilizers for sustainable crop production. In Biotechnology of Biofertilizers; Kannayan, S., Ed.; Narosa Publication House: New Delhi, India, 2002; pp. 9–49. [Google Scholar]
- Atimanav, G.; Adholeya, A. AM inoculation of five tropical fodder crops and inoculum production in unfertilized soil amended with organic matter. Biol. Fertil. Soils 2002, 35, 214–218. [Google Scholar]
- Clarson, D. Potash Biofertilizer for Ecofriendly Agriculture; Agro-clinic and Research Centre: Kottayam, India, 2004; pp. 98–110. [Google Scholar]
- Malboobi, M.A.; Owlia, P.; Behbahani, M.; Sarokhani, E.; Moradi, S.; Yakhchali, B.; Deljou, A.; Heravi, K.M. Solubilization of organic and inorganic phosphates by three highly efficient soil bacterial isolates. World J. Microbiol Biotechnol. 2009, 25, 1471–1477. [Google Scholar] [CrossRef]
- Abou El-Khair, E.E.; Nawar, D.A.S.; Ismail, H.M.E. Effect of irrigation water quantity and farmyard manure on potato plant grown in sandy soil. Egypt. J. Agric. Res. 2011, 89, 317–334. [Google Scholar] [CrossRef]
- El-Sayed, S.F.; Hassan, H.A.; El-Mogy, M.M. Impact of Bio- and Organic Fertilizers on Potato Yield, Quality and Tuber Weight Loss after Harvest. Potato Res. 2015, 58, 67–81. [Google Scholar] [CrossRef]
- Jen-Hshuan, C. The combined use of chemical and organic fertilizers and/or biofertilizer for crop growth and soil fertility. In International Workshop on Sustained Management of the Soil Rhizosphere System for Efficient Crop Production and Fertilizer Use; Land Development Department: Bangkok, Thailand, 2006; Volume 16–20, pp. 1–10. [Google Scholar]
- Sandhu, N.; Sethi, M.; Kumar, A.; Dang, D.; Singh, J.; Chhuneja, P. Biochemical and genetic approaches improving nitrogen use efficiency in cereal crops: A review. Front. Plant Sci. 2021, 12, 657629. [Google Scholar] [CrossRef] [PubMed]
- Elhakim, S.A.Z.; El-Mesirry, D.S.; Yousry, M.M. Impact of potassium fertilization rates and Bacillus circulans on the growth, yield and color of processed potato (Solanum tuberosum L.) tubers chips. Alex. Sci. Exch. J. 2016, 37, 594–605. [Google Scholar]
- Zaghloul, R.A. Biofertilization and organic manuring efficiency on growth and yield of potato plants (Solanum tuberosum L.). In Recent Technologies in Agriculture, Proceedings of the 2nd Congress, Banha Branch, Egypt, 28–30 October 2001; Faculty of Agriculture, Cairo University: Giza Governorate, Egypt, 2002; pp. 79–95. [Google Scholar]
- Bottini, R.; Cassan, F.; Piccoli, P. Gibberellin production by bacteria and its involvement in plant growth promotion and yield increase. Appl. Microbiol. Biotechnol. 2004, 65, 497–503. [Google Scholar] [CrossRef]
- EL-Desuki, M.; Omaima, M.M.; Sawan. Effect of mineral fertilizers and sulphur application on growth, yield and quality of onion bulb. Ann. Agric. Sci. Moshtohor 2001, 39, 617–628. [Google Scholar]
- El-Desuki, M. Response of onion plants to humic acid and mineral fertilizers application. Ann. Agric. Sci. Moshtohor 2004, 42, 1955–1964. [Google Scholar]
- EL-Desuki, M.; Mahmoud, A.R.; Hafiz, M.M. Response of onion plants to minerals and biofertilizers application. Res. J. Agric. Biol. Sci.. 2006, 2, 292–298. [Google Scholar]
- Sundaravelu, S.; Muthukrishinan, T. Effect of seed treatment with Azospirillum and gibberellic acid on the growth and yield of radish. South India Hortic. 1993, 41, 212–213. [Google Scholar]
- Yogita Ram, R.B. Interaction effect of chemical and bio-fertilizers on growth and yield of onion (Allium cepa L.). HortFlora Res. Spectr. 2012, 1, 239–243. [Google Scholar]
- Yadav, K.S.; Nehra, B.K.; Lkshminarayana, K.; Malk, Y.S.; Narendra, S. Role of Azotobacter Bio-Fertilizer in Seed Production of Onion; National Horticultural Research and Development Foundation: Nashik, India, 2003; Volume 23, pp. 19–22. [Google Scholar]
- Pradu, I.; Narwadkar, P.R.; Sajindranath, A.K.; Jadhav, R.S. Correlation studies of Okra. J. Soils Crops 2003, 13, 170–171. [Google Scholar]
- Oyeyiola, G.P. Rhizosphere bacterial flora of Amaranthus hybridus. Res. J. Microbiol. 2010, 5, 137–143. [Google Scholar] [CrossRef][Green Version]
- Himanni, B.; Gupta, P.K.; Soni, P.L. Extraction, purification and characterization of galactomannan from Prosopisjuli flora (SW.) DC. Seed polysaccharides. Int. J. Sci. Env. Technol. 2013, 2, 708–724. [Google Scholar]
- Aysan, Y.; Karatas, A.; Cinar, O. Biological control of bacterial stem rot caused by Erwinia chrysanthemi on tomato. J. Crop Prot. 2003, 22, 807–811. [Google Scholar] [CrossRef]
- Ryan, A.D.; Kinkekl, L.L.; Schottel, J.L. Effect of pathogen isolate, potato cultivar, and antagonist strain on potato scab severity and biological control. Biocontrol Sci. Technol. 2004, 14, 301–311. [Google Scholar] [CrossRef]
- Brimner, T.A.; Boland, G.J. A review of the non-target effects of fungi used to biologically control plant diseases. Agric. Ecosyst. Environ. 2003, 100, 3–16. [Google Scholar] [CrossRef]
- Couillerot, O.; Prigent-Combaret, C.; Caballero-Mellado, J.; Moënne-Loccoz, Y. Pseudomonas fluorescens and closely related fluorescent pseudomonads as biocontrol agents of soil-borne phytopathogens. Lett. Appl. Microbiol. 2009, 48, 505–512. [Google Scholar] [CrossRef] [PubMed]
- Wani, A.H.; Un-Nisa, T. Management of black mold rot of onion. Mycopathologia 2011, 9, 49. [Google Scholar]
- Burdman, S.; Jurkevitch, E.; Okon, Y. Recent advances in the use of plant growth promoting rhizobacteria (PGPR) in agriculture. In Microbial Interactions in Agriculture and Forestry; Science Publishers Inc.: Calicut, India, 2000; Volume II, pp. 229–250. [Google Scholar]
- Mandic, L.; Djukic, D.; Beatovic, I.; Jovovic, Z.; Pesakovic, M.; Stevovic, V. Effect of different fertilizers and biofertilizers on the microbial activity and productivity of soil under potato cultivation. Afr. J. Biotechnol. 2011, 10, 6954–6960. [Google Scholar]
- Javoreková, S.; Maková, J.; Medo, J.; Kovácsová, S.; Charousová, I.; Horák, J. Effect of bio-fertilizers application on microbial diversity and physiological profiling of microorganisms in arable soil. Eurasian J. Soil Sci. 2015, 6, 54–61. [Google Scholar] [CrossRef]
- Nayak, N.; Sar, K.; Sahoo, B.K.; Mahapatra, P. Beneficial effect of effective microorganism on crop and soil-a review. J. Pharmacogn. Phytochem. 2020, 9, 3070–3074. [Google Scholar]
- Ngilangil, L.E.; Vilar, D.A. Effective Microorganisms as Remediation for Marginal Soil in the Philippines. Chem. Eng. Trans. 2020, 78, 153–255. [Google Scholar]
- Gang, W.; Ying, R.; Xuanjiao, B.; Yuying, S.; Jianping, H. Contributions of Beneficial Microorganisms in Soil Remediation and Quality Improvement of Medicinal Plants. Plants 2022, 11, 3200. [Google Scholar]
- Buyer, J.S.; Teasdale, J.R.; Roberts, D.P.; Zasada, I.A.; Maul, J.E. Factors affecting soil microbial community structure in tomato cropping systems. Am. J. Agric. Biol. Sci. 2010, 42, 831–841. [Google Scholar] [CrossRef]
- Kumar, V.; Behl, R.K.; Narula, N. Establishment of phosphate-solubilizing strains of Azotobacter chroococcumin the rhizosphere and their effect on wheat cultivars under greenhouse conditions. Microbiol. Res. 2001, 156, 87–93. [Google Scholar] [CrossRef]
- Ramalakshmi, A.; Iniyakumar, M.; Anthoni Raj, S. Influence of biofertilizers on soil physico-chemical and biological properties during cropping period. Asian J. Biol. Sci. 2008, 3, 348–351. [Google Scholar]
- Hamdia, M.A.; Shaddad, M.; Doaa, M. Mechanisms of salt tolerance and interactive effects of Azospirillum brasilense inoculation on maize cultivars grown under salt stress conditions. Environ. Microbiol. 2005, 7, 1839–1846. [Google Scholar] [CrossRef]
- Adesemoye, A.; Torbert, H.; Kloepper, J. Enhanced plant nutrient use efficiency with PGPR and AMF in an integrated nutrient management system. Can. J. Microbiol. 2008, 54, 876–886. [Google Scholar] [CrossRef]
- Egamberdiyeva, D. The effect of plant growth promoting bacteria on growth and nutrient uptake of maize in two different soils. Appl. Soil Ecol. 2007, 36, 184–189. [Google Scholar] [CrossRef]
- Gopinath, K.A.; Saha, S.; Mina, B.L.; Pande, H.; Kumar, N.; Srivastva, A.K.; Gupta, H.S. Yield potential of garden pea (Pisum sativum L.) varieties, and soil properties under organic and integrated nutrient management systems. Arch. Agron. Soil Sci. 2009, 55, 157–167. [Google Scholar] [CrossRef]
- Jaipaul, S.S.; Dixit, A.K.; Sharma, A.K. Growth and yield of capsicum and garden pea as influenced by organic manures and biofertilizers. Ind. J. Agric. Sci. 2011, 81, 637–642. [Google Scholar]
- Berger, R.; Stamford, N.P.; Santos, C.E.R.S.; Freitas, A.D.S.; Franco, L.O.; Stamford, T.C.M. Plant and soil characteristics affected by biofertilizers from rocks and organic matter inoculated with diazotrophic bacteria and fungi that produce chitosan. J. Soil Sci. Plant Nut. 2013, 13, 592–603. [Google Scholar] [CrossRef]
- Kleber, M.; Bourg, I.C.; Coward, E.K.; Hansel, C.M.; Myneni, S.C.; Nunan, N. Dynamic interactions at the mineral—Organic matter interface. Nat. Rev. Earth Environ. 2021, 2, 402–421. [Google Scholar] [CrossRef]
- Abd El-Ghany, B.F.; Arafa, R.A.M.; El-Rahmany, T.A.; El-Shazly, M.M. Effect of some soil microorganisms on soil properties and wheat production under north Sinai conditions. J. Appl. Sci. Res. 2010, 6, 559–579. [Google Scholar]
- Li, L.; Yang, T.; Liu, R.; Redden, B.; Maalouf, F.; Zong, X. Food legume production in China. Crop J. 2017, 5, 115–126. [Google Scholar] [CrossRef]
- Zeynep, D. Effects of microbial bio-fertilizers on soil physicochemical properties under different soil water regimes in greenhouse grown eggplant (Solanum Melongena L.). Commun. Soil Sci. Plant Anal. 2020, 51, 1888–1903. [Google Scholar]
- Hala, H.A.; Shaban, K.A.; Esmaeil, M.A.; Abdel Fattah, A.K. Influence of Organic and Biofertilizers on Some Soil Chemical Properties, Wheat Productivity and Infestation Levels of Some Piercing-Sucking Pests in Saline Soil. Middle East J. Agric. Res. 2020, 9, 586–598. [Google Scholar]

| Attribute | Value |
|---|---|
| Sand (%) | 41.62 |
| Silt (%) | 28.13 |
| Clay (%) | 30.25 |
| Texture class | Clay loam |
| Bulk density (Mg m−3) | 1.27 |
| pH 1:2.5 (water) | 8.15 |
| ECe (dS m−1) | 5.04 |
| OC (g kg−1) | 8.4 |
| TN (g kg−1) | 1.13 |
| ava. P (g kg−1) | 22 |
| ava. K (g kg−1) | 206 |
| Treatment | Dose |
|---|---|
| T1 | Mycorrhizae + 75% NPK |
| T2 | EM + 75% NPK |
| T3 | 75% NPK |
| T4 | 100% NPK |
| Treatment | Dose | Bulk d. (Mg m−3) | pH 1:2.5 (Water) | ECe (dS m−1) | SOC (g kg−1) | TN (g kg−1) | ava. P (g kg−1) | ava. K (g kg−1) |
|---|---|---|---|---|---|---|---|---|
| T1 | Mycorrhizae + 75%NPK | 1.18 ± 0.03 ab | 8.08 ± 0.02 b | 3.66 ± 0.14 b | 10.02 ± 0.17 a | 1.01 ± 0.07 bc | 24.09 ± 0.73 c | 275 ± 9.42 a |
| T2 | EM + 75% NPK | 1.15 ± 0.04 b | 8.16 ± 0.02 a | 3.31 ± 0.13 c | 9.09 ± 0.13 c | 0.97 ± 0.07 c | 26.12 ± 0.61 b | 226 ± 4.58 b |
| T3 | 75% NPK | 1.22 ± 0.04 a | 8.16 ± 0.02 a | 3.51 ± 0.10 bc | 8.69 ± 0.15 d | 1.12 ± 0.04 ab | 21.00 ± 0.42 d | 175 ± 8.19 d |
| T4 | 100% NPK | 1.23 ± 0.04 a* | 8.13 ± 0.02 a | 3.98 ± 0.09 a | 8.71 ± 0.23 d | 0.98 ± 0.06 c | 23.98 ± 0.68 c | 200 ± 9.54 c |
| Treatment | Potato | Onion | ||||||
|---|---|---|---|---|---|---|---|---|
| Bacteria (×105 CFU g−1) | Fungi (×104 CFU g−1) | Actinomycetes (×105 CFU g−1) | Mycorrhizal Colonization (%) | Bacteria (×105 CFU g−1) | Fungi (×104 CFU g−1) | Actinomycetes (×105 CFU g−1) | Mycorrhizal Colonization (%) | |
| T1 | 188 | 60 | 81 | 82 | 200 | 66 | 87 | 88 |
| T2 | 201 | 50 | 57 | 65 | 177 | 55 | 56 | 55 |
| T3 | 144 | 45 | 95 | 32 | 152 | 54 | 88 | 40 |
| T4 | 140 | 38 | 42 | 33 | 147 | 41 | 52 | 28 |
| Before planting | 88 | 15 | 12 | 14 | 78 | 14 | 14 | 10 |
Disclaimer/Publisher’s Note: The statements, opinions and data contained in all publications are solely those of the individual author(s) and contributor(s) and not of MDPI and/or the editor(s). MDPI and/or the editor(s) disclaim responsibility for any injury to people or property resulting from any ideas, methods, instructions or products referred to in the content. |
© 2023 by the authors. Licensee MDPI, Basel, Switzerland. This article is an open access article distributed under the terms and conditions of the Creative Commons Attribution (CC BY) license (https://creativecommons.org/licenses/by/4.0/).
Share and Cite
Abdel Aal, A.M.K.; Assiri, M.E.; Al-Farga, A.; Moustafa, Y.M.M.; Hammam, A.A.; Haddad, S.A.; Abdelkarim, N.S. Exploration of the Benefits of Biofertilizers for Attaining Food Security in Egypt’s Agriculture. Agronomy 2023, 13, 2477. https://doi.org/10.3390/agronomy13102477
Abdel Aal AMK, Assiri ME, Al-Farga A, Moustafa YMM, Hammam AA, Haddad SA, Abdelkarim NS. Exploration of the Benefits of Biofertilizers for Attaining Food Security in Egypt’s Agriculture. Agronomy. 2023; 13(10):2477. https://doi.org/10.3390/agronomy13102477
Chicago/Turabian StyleAbdel Aal, Ahmed M. K., Mazen E. Assiri, Ammar Al-Farga, Yasser M. M. Moustafa, Amr A. Hammam, Samir A. Haddad, and Nesrin S. Abdelkarim. 2023. "Exploration of the Benefits of Biofertilizers for Attaining Food Security in Egypt’s Agriculture" Agronomy 13, no. 10: 2477. https://doi.org/10.3390/agronomy13102477
APA StyleAbdel Aal, A. M. K., Assiri, M. E., Al-Farga, A., Moustafa, Y. M. M., Hammam, A. A., Haddad, S. A., & Abdelkarim, N. S. (2023). Exploration of the Benefits of Biofertilizers for Attaining Food Security in Egypt’s Agriculture. Agronomy, 13(10), 2477. https://doi.org/10.3390/agronomy13102477

